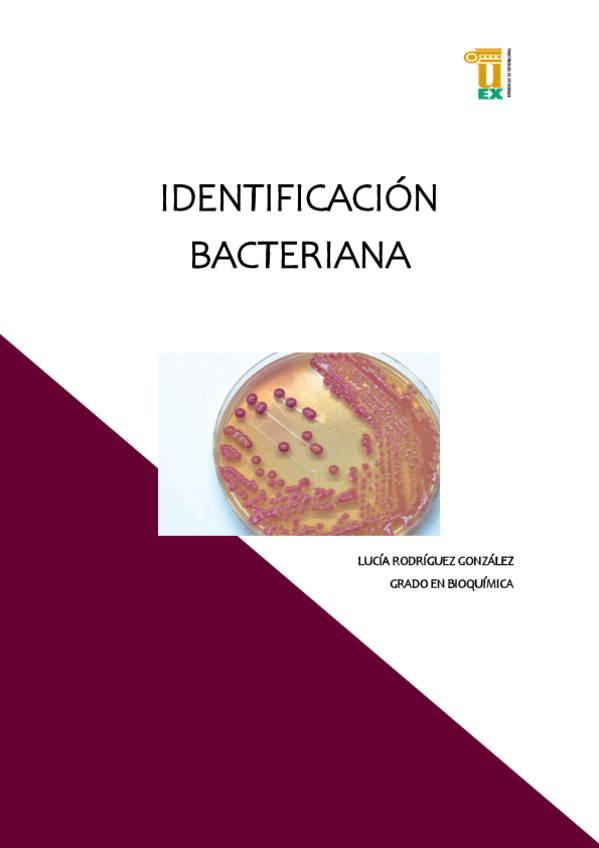

Microbiología
apuntes
-
Apuntes Microbiología
He publicado nuevos apuntes de 2º Microbiología: Apuntes Microbiología
He publicado nuevos practicas de 2º Microbiología: Informe-microbiologia-Lucia-Correas-Nogues.pdf
He publicado nuevos examenes de 2º Microbiología: examen-micro-mayo-2025.docx
He publicado nuevos apuntes de 2º Microbiología: informe-de-practica.pdf
apuntes
-
Resúmen Bacterias y Hongos
He publicado nuevos apuntes de 2º Microbiología: Resúmen Bacterias y Hongos
He publicado nuevos apuntes de 2º Microbiología: resumen-gammaproteobacterias.pdf
apuntes
-
Formulario microbiología
He publicado nuevos apuntes de 2º Microbiología: Formulario microbiología
apuntes
-
Temario
He publicado nuevos apuntes de 2º Microbiología: Temario
He publicado nuevos apuntes de 2º Microbiología: informe-microbiologis-Karla..pdf
He publicado nuevos practicas de 2º Microbiología: INFORME-PRACTICAS-DE-MICROBIOLOGIA.pdf
He publicado nuevos practicas de 2º Microbiología: Informe-practicas.pdf
apuntes
-
Apuntes (2021-2022)
He publicado nuevos apuntes de 2º Microbiología: Apuntes (2021-2022)
apuntes
-
Apuntes Microbiología
He publicado nuevos apuntes de 2º Microbiología: Apuntes Microbiología
practicas
-
Informe de Microbiología
He publicado nuevos practicas de 2º Microbiología: Informe de Microbiología
He publicado nuevos apuntes de 2º Microbiología: Taxonomia-bacteriana.pdf
He publicado nuevos apuntes de 2º Microbiología: Reproduccion-y-crecimiento-bacteriano.pdf
He publicado nuevos apuntes de 2º Microbiología: Nutricion-bacteriana.pdf
He publicado nuevos apuntes de 2º Microbiología: Tema-4-Virologia-basica.pdf
He publicado nuevos apuntes de 2º Microbiología: Tema-2-Estructura-y-funcion-de-la-celula-bacteriana.pdf
He publicado nuevos apuntes de 2º Microbiología: Tema-1-Concepto-de-microbiologia.pdf
He publicado nuevos examenes de 2º Microbiología: Examen-micro-vet-2022.pdf
practicas
-
Informe Practicas Micro
He publicado nuevos practicas de 2º Microbiología: Informe Practicas Micro
He publicado nuevos examenes de 2º Microbiología: Preguntas-nuevas-micro-2022.pdf
He publicado nuevos practicas de 2º Microbiología: Informe-Practicas-Microbiologia.pdf
apuntes
-
Apuntes Temas 1-13
He publicado nuevos apuntes de 2º Microbiología: Apuntes Temas 1-13
examenes
-
Exámenes Micro
He publicado nuevos examenes de 2º Microbiología: Exámenes Micro
apuntes
-
Microbiología
He publicado nuevos apuntes de 2º Microbiología: Microbiología
apuntes
-
APUNTES MICROBIOLOGÍA
He publicado nuevos apuntes de 2º Microbiología: APUNTES MICROBIOLOGÍA
He publicado nuevos apuntes de 2º Microbiología: Sintesis-del-peptido-glicano.docx
examenes
-
Exámenes
He publicado nuevos examenes de 2º Microbiología: Exámenes
apuntes
-
Microbiología
He publicado nuevos apuntes de 2º Microbiología: Microbiología
apuntes
-
Apuntes microbiología - JONI
He publicado nuevos apuntes de 2º Microbiología: Apuntes microbiología - JONI
apuntes
-
Apuntes Microbiología - Carlos B
He publicado nuevos apuntes de 2º Microbiología: Apuntes Microbiología - Carlos B
practicas
-
Prácticas Microbiología
He publicado nuevos practicas de 2º Microbiología: Prácticas Microbiología